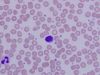

Last additions |

Arteriole - histology slideFeb 19, 2010
|
|

Arteriole - histology slideFeb 19, 2010
|
|

Bone - histology slideFeb 19, 2010
|
|

Bone - histology slideFeb 19, 2010
|
|

Bone - histology slideFeb 19, 2010
|
|

Bone - histology slideFeb 19, 2010
|
|

Bone - histology slideFeb 19, 2010
|
|

Compact Bone - histology slideFeb 19, 2010
|
|

Compact Bone - histology slideFeb 19, 2010
|
|
Blood - histology slideFeb 11, 2010
|
|

Neutrophils - histology slideFeb 11, 2010
|
|

Lymphocyte - histology slideFeb 11, 2010
|
|
4024 files on 336 page(s) |
 |
 |
 |
 |
 |
7 |  |
 |
 |
 |
|